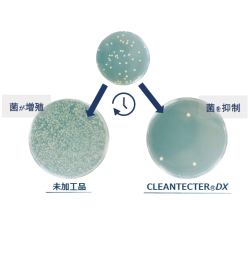
【新光触媒シリーズ】CLEANTECTER DX

ランドリー・クリーニング技術に関連する気になるカタログにチェックを入れると、まとめてダウンロードいただけます。
抗菌・防臭洗浄の強化とは?課題と対策・製品を解説

目的・課題で絞り込む
カテゴリで絞り込む
機械 |
機器・部品 |
資材 |
環境・節電対策 |
産業クリーニング |
ICT・決済システム |
車両・店��舗設備 |
特殊クリーニング |
その他ランドリー・クリーニング技術 |

クリーニング店における抗菌・防臭洗浄の強化とは?
各社の製品
絞り込み条件:
▼チェックした製品のカタログをダウンロード
一度にダウンロードできるカタログは20件までです。
【クリーニング店向け】マリモ・ボールⓇ
【クリーニング向け】スーパーアルカリイオン水生成装置
セルロース繊維用の抗菌防臭剤『バクトールUQL』
ネオM2NC
洗たく用洗剤『液体ビック バイオ酵素』<業務用>
クリーニング用、ランドリー用洗剤
マットハイザー【洗浄後のマットレスを短時間に乾燥させる衛生機械】
繊維用柔軟剤『パラファインAPC/CLD/SSM』
マット乾燥を衛生的に!感染予防支援機『マットハイザー』
【ファインバブル導入事例】東芝ライフスタイル株式会社 様
製品カタログ 薬剤
室内干し用液体洗濯洗剤『キ�レイ201』
消臭除菌ミストシャワー『HAL・SHOWER Lite』
【付着を防止し、簡単除去する!】「花粉��・砂ほこり防汚スプレー」
ドライ溶剤消臭剤『ドライで爽快』
香り持続加工剤「クインライトFRG」
オチルーラ 作業着用
部屋干し臭対策・抗菌防臭加工剤「クインライトRMD」
【クリーニング向け】活水器『ディレカ』
汗やタバコなど、衣類に染み付いた臭いをしっかり消臭!『イリス』
抗菌防臭加工剤『センシルAFU-05』
【導入事例】洗濯のプロ
小型オゾン発生装置『パーフェクト・クリーンモア PCM-10F』
抗菌・消臭・防汚加工【着ているだけで消臭効果!】※資料進呈中
タバコのにおい対策に好適『HAL・SHOWER Lite』
洗濯と同時に細菌・ウイルスの除去を実現「ウイルスウォッシュ」
Tonello(トネロ)社 オゾン殺菌キャビネット
ランドリー用液体洗剤『アクアウォッシュ クリア』<業務用>
液体洗浄強化剤『アル��カリ助剤 for カイオス』
【新光触媒シリーズ】CLEANTECTER DX
クリーニング用抗菌性消臭薬剤「ノーズパル CL-プラス」
精練洗浄剤『ソルゲン LL』
温風循環式 乾燥機 「ハマタケ型 業務用 被服乾燥機」
抗菌防臭加工剤『センシルAFU-08』
【資料】洗剤、洗浄剤およびケア製品用添加剤
抗菌防臭・消臭加工『シュレス』
電解水活用による環境配慮型クリーニング ~コインランドリーなど~
洗濯洗剤『ニューデノミック』
前処理洗剤『とっても爽快』
梅雨に悩まされる洗濯の悩み!「生乾きのニオイ」問題
抗菌防臭加工『Ag Fresh��(R)』
クリーニング業界でコストダウンが実現!UFB DUALのご紹介
消臭加工剤『センカメルセンシリーズ』
私物洗濯専用 除菌・消臭剤『BA-CLEAN』
マルチ消臭加工剤『パラファイン NS-385』
OEM製品のご案内『HAL・SHOWER Lite』
省エネ×時短乾燥!介護マット乾燥装置『マットハイザー』

お探しの製品は見つかりませんでした。
1 / 1
クリーニング店における抗菌・防臭洗浄の強化
クリーニング店における抗菌・防臭洗浄の強化とは?
クリーニング店の抗菌・防臭洗浄の強化とは、衣類に付着した細菌やカビの増殖を抑制し、不快な臭いを元から除去することで、より衛生的で快適な衣類を提供するサービスを指します。消費者の健康意識の高まりや、衣�類を清潔に保ちたいというニーズに応えるための重要な取り組みです。
課題
臭いの原因菌への対応不足
衣類に付着した臭いの原因となる細菌やカビに対して、表面的な洗浄だけでは根本的な除去が難しい場合がある。
抗菌・防臭効果の持続性の課題
一度の洗浄で得られた抗菌・防臭効果が、着用や保管中に失われやすく、長期的な効果が期待できない。
特殊な汚れや臭いへの対応限界
汗や皮脂、体臭など、衣類に染み付いた頑固な臭いや、特定の菌による汚れに対して、従来の洗浄方法では十分な効果を発揮できないことがある。
顧客への効果訴求の難しさ
抗菌・防臭効果を目に見える形で示すことが難しく、顧客に対してその価値やメリットを効果的に伝えるための工夫が必要となる。
対策
高機能洗浄剤の導入
強力な殺菌・除菌成分を含む、衣類に優しい特殊な洗浄剤を導入し、臭いの原因菌を徹底的に除去する。
抗菌・防臭加工のオプション提供
洗浄後の衣類に、持続性のある抗菌・防臭効果を付与する加工をオプションとして提供し、清潔さを長持ちさせる。
専門的な消臭技術の活用
オゾン発生装置や特殊な消臭剤を使用するなど、衣類に染み付いた頑固な臭いを分解・除去する専門的な技術を導入する。
効果を可視化するサービス展開
洗浄前後の臭いレベルの比較や、抗菌効果の試験結果などを提示し、顧客に安心感と信頼感を与えるサービスを提供する。
対策に役立つ製品例
業務用強力除菌洗浄剤
衣類に付着した広範囲の細菌やカビを効果的に除去し、臭いの元を断つことで、洗浄効果を高める。
持続型抗菌防臭コーティング剤
衣類の繊維に浸透し、長期間にわたって細菌の増殖を抑制し、不快な臭いの発生を防ぐ効果を提供する。
高性能オゾン脱臭装置
衣類に染み付いた頑固な臭いを分子レベルで分解し、無臭化する能力を持つため、特殊な臭いにも対応できる。
消臭効果測定キット
洗浄や加工の効果を数値化・可視化することで、顧客に対してサービスの品質と効果を具体的に示すことができる。
⭐今週のピックアップ

読み込み中